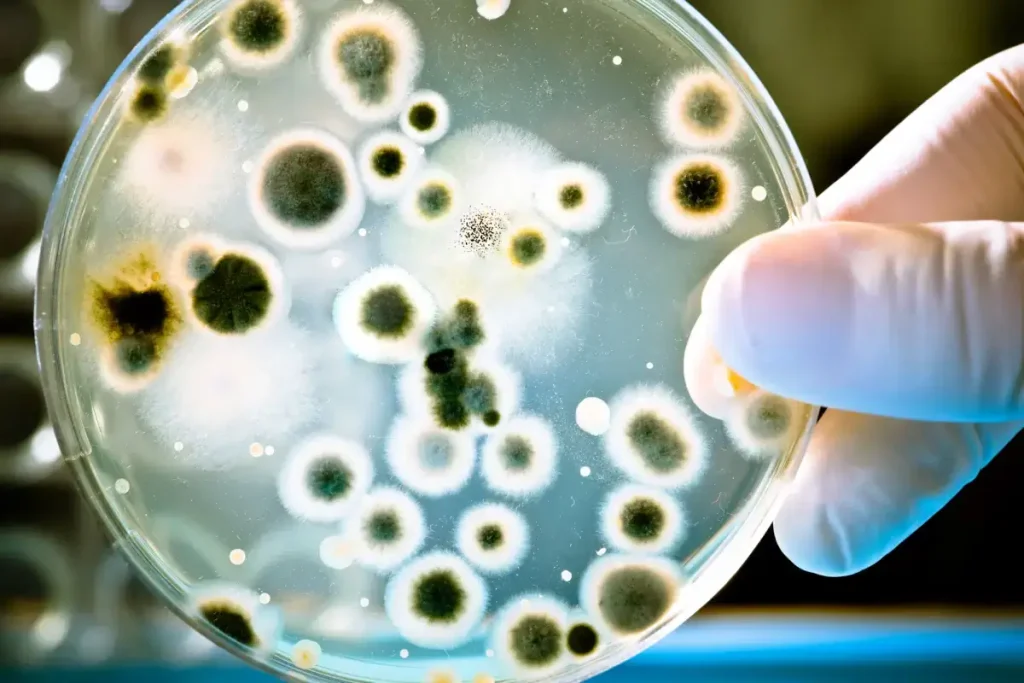
Micro-evolution: Petri Dish with Bacteria Culture

Evolution works through a process akin to a color spectrum gradually shifting from red to blue, where minute changes accumulate over time to result in significant transformations. This concept offers a vivid understanding of micro-evolution, characterized by small and subtle adjustments that are almost imperceptible on their own. Over extended periods, these incremental changes lead to macro-evolution, the broader and more noticeable shifts in species and traits. This analogy not only clarifies the evolutionary process but also helps dispel common misconceptions, illustrating the seamless and natural progression from one evolutionary state to another.
Illustrating Macro-Evolution Through Color Metaphor

Here is the text on the image above, with colors from red to blue:
We all can agree (save for the severely color-blind) that this text is red.
We can also similarly agree that this text is blue.
So tell me: what was the first purple word in the block of text above? What’s the first blue word? Remember, if macro-evolution simply can not happen then you’re saying the words you are reading now are still red.
Evolution
A fundamental concept in biology, evolution is the process through which species change over time due to genetic variations and environmental factors. At the core of this concept is the idea that all life forms share a common ancestor and that these life forms have diversified and adapted over millions of years. This process is driven by mechanisms such as natural selection, where individuals with advantageous traits are more likely to survive and reproduce, thereby passing these traits to future generations.
The study of evolution is not just about understanding the past; it also offers insights into the present and future of biodiversity. It explains the diversity of life on Earth, from the tiniest microorganisms to the largest mammals, and even the human species. Evolutionary theory helps us understand why certain species thrive while others go extinct, and it provides crucial information for areas such as medicine, where understanding the evolutionary history of pathogens can aid in the development of treatments and vaccines.
Two key components of evolutionary theory are microevolution and macroevolution. Micro-evolution refers to small-scale changes within a species, often observable within a human lifetime. These changes can include variations in color, size, or other traits within a population. Macroevolution, on the other hand, encompasses more significant evolutionary changes that can lead to the emergence of new species. This process is typically much slower, occurring over thousands or millions of years.
Micro-evolution
Micro-evolution is the process of evolutionary change within a species or small group of organisms over a relatively short period. It’s the accumulation of minor genetic variations that do not necessarily lead to the creation of new species but instead bring about variations within the species. This concept is pivotal in understanding the evolutionary process as it lays the groundwork for more significant evolutionary changes, known as macro-evolution.
The primary drivers of micro-evolution are mutations, genetic drift, gene flow, and natural selection. Mutations are random changes in the DNA sequence, which can lead to new genetic variations within a population. Genetic drift refers to random fluctuations in the frequencies of alleles (different forms of a gene) within a small population. This can lead to significant changes over time, particularly in isolated populations. Gene flow, or the transfer of genes between populations, can introduce new genetic material into a group, leading to increased genetic diversity. Natural selection, perhaps the most well-known mechanism, involves the differential survival and reproduction of individuals due to differences in phenotype, or observable characteristics.
Micro-evolution is evident in various observable phenomena. For example, the development of antibiotic resistance in bacteria is a clear instance of micro-evolution. Bacteria rapidly evolve resistance to antibiotics, demonstrating how quickly and effectively micro-evolutionary changes can occur. Similarly, the changes in beak shapes among Darwin’s finches in the Galápagos Islands, responding to different food sources, are another classic example of micro-evolution in action.
By understanding micro-evolution, we gain insight into the initial steps of how species adapt to their environments and how these small changes can accumulate over time to drive more significant evolutionary processes. It is the foundational mechanism that sets the stage for the broader patterns of change observed in the natural world under the umbrella of macro-evolution.
The Gradual Transition to Macroevolution
Macroevolution, a concept integral to understanding the broad patterns of life’s history, refers to the significant evolutionary changes that occur over extended periods, often resulting in the emergence of new species. This process represents a cumulative effect of the smaller, micro-evolutionary changes, but on a greater scale. The transition from micro to macro-evolution is gradual and often imperceptible in a human lifetime, yet it is a pivotal aspect of evolutionary biology.
The transition from micro to macroevolution is not a sudden leap but rather a continuum of accumulated changes. Over thousands or millions of years, the small variations that characterize micro-evolution can lead to substantial differences, eventually resulting in distinct species. This process can be driven by various factors, including geographical isolation, environmental changes, and the continuous accumulation of genetic differences.
One classic example of this transition is the evolution of modern birds from theropod dinosaurs (source). Initially, small changes, such as feathers for insulation or display, evolved through micro-evolutionary processes. Over time, these changes, coupled with other adaptations like modified bone structures for flight, led to the emergence of a distinctly new group of animals – the birds.

The gradual nature of this process makes it challenging to pinpoint the exact moment when one species becomes another, mirroring the difficulty in identifying the precise point where a color changes in a gradient. This gradual shift is analogous to the color change from red to blue in the provided text, where each minute change is hard to discern individually, but over a span, the difference becomes evident.
Understanding the gradual transition to macro-evolution helps demystify how complex life forms and diverse ecosystems have developed over Earth’s history. It underscores the fact that significant evolutionary changes are the product of many small, incremental steps over vast timescales. This perspective is essential for appreciating the dynamic and ongoing nature of evolution, revealing the interconnectedness of all living organisms through their shared evolutionary journey.
How evolution works: a colorful analogy
The metaphor of a color gradient transitioning from red to blue offers a powerful illustration of the concept of macro-evolution. Just as it is difficult to discern the exact point where red becomes blue in a gradient, so too is it challenging to pinpoint when a series of micro-evolutionary changes lead to a new species – a process known as macro-evolution. This metaphor serves as an effective tool to visualize the gradual and continuous nature of evolutionary change.
In this analogy, each slight change in color represents a small genetic variation within a species, akin to micro-evolution. Initially, these changes are almost imperceptible, just as minor genetic alterations may not significantly impact a species’ characteristics. However, as more changes accumulate, the overall effect becomes more pronounced. Over a long period, these incremental shifts result in a color that is distinctly different from the starting hue. Similarly, in biology, accumulated micro-evolutionary changes over thousands or millions of years can result in organisms that are substantially different from their ancestors, leading to the formation of new species.
This color transition metaphor helps demystify the concept of macro-evolution. It demonstrates that macro-evolution does not imply a sudden or dramatic leap from one species to another. Instead, it is the culmination of numerous, small changes that occur over extended periods. This gradual process echoes the way natural selection and genetic drift operate, slowly molding species to adapt to their environments and eventually giving rise to new forms of life.
By using this color gradient as a representation, the abstract concept of macroevolution becomes more tangible and understandable. It reinforces the idea that the diversity of life observed today is the result of a long, continuous process of evolution, marked by a series of small, incremental changes that collectively yield significant transformations over geological time scales.
Common Misconceptions About Macro-Evolution
Misunderstandings about macro-evolution frequently stem from misconceptions about the nature of evolutionary change and the time scales over which it operates.
A prevalent misconception is the idea that macro-evolution involves drastic, immediate changes or that it implies the direct transformation of one fully-formed species into another distinctly different species. This is a misinterpretation of the evolutionary process. Macro-evolution does not mean, for instance, that a dog would be a direct offspring of a completely different canine-like species, or, more absurdly, that a cat could evolve directly from a dog. These ideas stem from a fundamental misunderstanding of how evolutionary processes work.
Macroevolution, in reality, is about the cumulative effect of small, incremental changes (micro-evolution) over vast periods. These changes, while minor and often imperceptible in the short term, can lead to significant differences over thousands or millions of years. It is a process of gradual change and diversification, not sudden leaps.

One major source of confusion arises from the expectations and arguments often presented by creationists, such as the demand for evidence of improbable creatures like a “crocoduck.” This notion reflects a misunderstanding of how evolutionary processes work; evolution does not predict nor support the emergence of such hybrid animals combining distinct species’ features in a simplistic or abrupt manner.
Macroevolution involves the gradual accumulation of small, incremental changes (micro-evolution) over extensive periods, not sudden, dramatic transformations. It’s not about a dog directly evolving from a different canine-like species, nor about a cat evolving from a dog. Such ideas misrepresent the nature of evolutionary change, suggesting implausible leaps between fully formed species rather than gradual adaptation and divergence.
Another significant point to clarify is the nature of fossils in the evolutionary timeline. Contrary to some misconceptions, every fossil can be considered a “transitional fossil.” Transitional (or intermediate) fossils are those that show intermediate traits between ancestral and derived species, and they are crucial in understanding the evolutionary pathways of different organisms. However, every species is always in a state of transition, adapting and changing. Therefore, all fossils, by capturing a species at a particular point in its evolutionary history, represent a part of the continuum of life’s evolutionary journey.
Additionally, it’s important to address the fallacy that macro-evolution is unsupported or controversial within the scientific community. The evidence for macro-evolution is extensive and multidisciplinary, including fossil records, genetic studies, and observations of morphological changes. These evidences collectively demonstrate the gradual transformations that have led to the diversity of life observed today.
In dispelling these misconceptions, it becomes clear that macro-evolution is a well-established, empirically supported aspect of biological science. It is a process of gradual change and diversification, fundamental to understanding the history and diversity of life on Earth. By comprehending these concepts, one can appreciate the scale and complexity of evolutionary processes that have shaped the natural world.
Sources
- Theropoda on Wikipedia
- “Paleontology: Theropod Dinosaurs and the Origin of Birds” on the University of Alberta website
- Microevolution on Wikipedia
- What is microevolution? on the University of California, Berkeley website
- What is macroevolution? on the University of California, Berkeley website
- Macroevolution on Wikipedia
- Macroevolution on the Oxford Bibliographies website